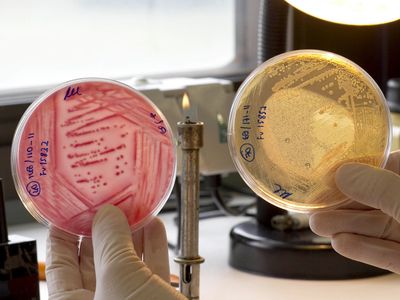

Za prvních osm měsíců letošního roku bylo v České republice hlášeno přes 200 případů invazivního pneumokokového onemocnění, více než 20 případů skončilo úmrtím pacienta. Žebříčkům nemocnosti vévodí Středočeský kraj, který hlásí již 32 pacientů, následován je Prahou a Jihočeským krajem, kde bylo shodně evidováno 22 případů.
„Ve srovnání s rokem 2010 se jedná o významný vzestup – před dvěma lety bylo u nás hlášeno 11 případů za celý rok, letos už 22,“ řekla Jitka Luňáčková z Krajské hygienické stanice České Budějovice. Dalšími kraji s vyšším počtem případů onemocnění za rok 2012 jsou Plzeňský kraj (21 případů) a Královéhradecký kraj (19 případů).
První příznaky invazivního pneumokokového onemocnění jsou podobné chřipce – teplota, zimnice, třesavka, bolesti hlavy a zvracení. Právě proto jsou pneumokoková onemocnění velmi zrádná. Pneumokok postihuje jednotlivé orgány a způsobuje závažné záněty středouší, těžké zápaly plic i pneumokokové meningitidy. Zvláště u starších osob může mít onemocnění závažný průběh.
„V Libereckém kraji bylo devět z deseti osob, které onemocněly pneumokokovou infekcí, starších 50 let. Ani jeden z pacientů nebyl proti invazivním pneumokokovým onemocněním očkován. V jednom případě došlo na následky onemocnění k úmrtí pacienta,“ uvedla Jana Prattingerová, vedoucí protiepidemického odboru Krajské hygienické stanice Libereckého kraje.
Podobná situace nastala i na Vysočině: „V kraji Vysočina bylo postiženo jedno dítě ve věku do pěti let, ostatní osoby byly starší 65 let. Na následky nákazy pneumokokovou infekcí zemřelo celkem pět mužů ve věku od 65 do 84 let,“ dodala Alena Dvořáková, vedoucí protiepidemického odboru Krajské hygienické stanice kraje Vysočina.
Onemocnění pneumokokovou infekcí lze předejít dostupným očkováním. Očkovací látka pokrývající základní spektrum deseti sérotypů je plně hrazená státem, na vakcínu s rozšířeným spektrem třinácti sérotypů je nutné si doplatit.
Streptococcus pneumoniae neboli pneumokok je bakterie, kterou je běžně osídlena sliznice úst, nosu a horních cest dýchacích mnoha lidí. Pneumokoka má ve svém nosohltanu více než 10 procent zdravých dospělých a až 60 procent dětí. Pneumokok těmto nosičům nezpůsobuje žádné problémy.
Pokud ale dojde k oslabení obranných mechanismů člověka, například při viróze, mohou pneumokoky proniknout do míst, kam nepatří, a způsobit tam závažnou infekci – například do plic, kde vyvolají pneumonii (zápal plic), nebo na mozkové obaly, kde způsobí meningitidu. Z méně závažných infekcí způsobují pneumokoky především zánět středního ucha (otitidu) u dětí.
Inkubační doba pneumokokového onemocnění je jeden až tři dny. Jedná se o kapénkovou infekci, to znamená, že se přenáší zejména těsným kontaktem, při kýchání, kašlání. Nakazit se je možné od člověka s pneumokokovou infekcí nebo od bacilonosiče.